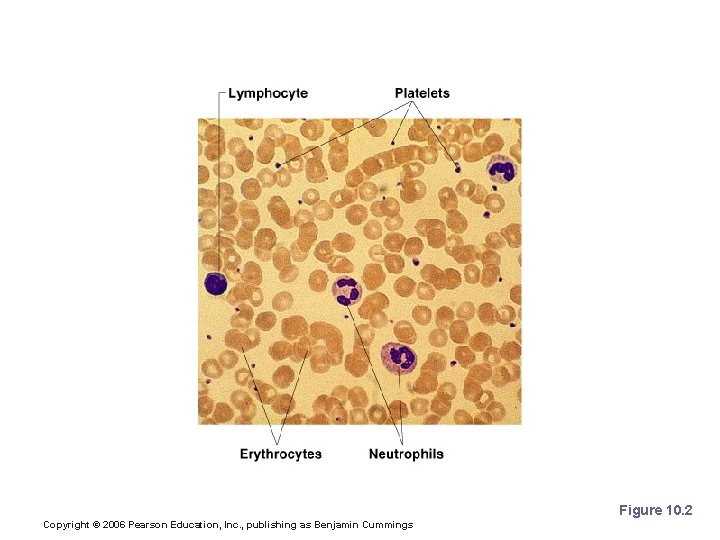
Photomicrograph of a Blood Smear Figure 10. 2 Copyright © 2006 Pearson Education, Inc.

10 Blood Power Point Lecture Slide Presentation by

10 Blood Power. Point® Lecture Slide Presentation by Jerry L. Cook, Sam Houston University ESSENTIALS OF HUMAN ANATOMY & PHYSIOLOGY EIGHTH EDITION ELAINE N. MARIEB Copyright © 2006 Pearson Education, Inc. , publishing as Benjamin Cummings

Blood § The only fluid tissue in the human body § Classified as a connective tissue § Living cells = formed elements § Non-living matrix = plasma Copyright © 2006 Pearson Education, Inc. , publishing as Benjamin Cummings

Blood Figure 10. 1 Copyright © 2006 Pearson Education, Inc. , publishing as Benjamin Cummings

Physical Characteristics of Blood § Color range § Oxygen-rich blood is scarlet red § Oxygen-poor blood is dull red § p. H must remain between 7. 35– 7. 45 § Blood temperature is slightly higher than body temperature Copyright © 2006 Pearson Education, Inc. , publishing as Benjamin Cummings

Blood Plasma § Composed of approximately 90 percent water § Includes many dissolved substances § Nutrients § Salts (metal ions such as K, Na, Cl, etc. ) § Respiratory gases (ALL gases, not just O 2 and CO 2) § Hormones § Proteins § Waste products Copyright © 2006 Pearson Education, Inc. , publishing as Benjamin Cummings

Plasma Proteins § Albumin – regulates osmotic pressure § Clotting proteins – help to stem blood loss when a blood vessel is injured § Antibodies – help protect the body from antigens Copyright © 2006 Pearson Education, Inc. , publishing as Benjamin Cummings

Formed Elements § Erythrocytes = red blood cells § Leukocytes = white blood cells § Platelets = cell fragments Copyright © 2006 Pearson Education, Inc. , publishing as Benjamin Cummings
Photomicrograph of a Blood Smear Figure 10. 2 Copyright © 2006 Pearson Education, Inc. , publishing as Benjamin Cummings

Characteristics of Formed Elements of the Blood Table 10. 2 Copyright © 2006 Pearson Education, Inc. , publishing as Benjamin Cummings

Characteristics of Formed Elements of the Blood Table 10. 2 Copyright © 2006 Pearson Education, Inc. , publishing as Benjamin Cummings

Erythrocytes (Red Blood Cells) § The main function is to carry oxygen § Anatomy of circulating erythrocytes § Biconcave disks § Essentially bags of hemoglobin § Anucleate (no nucleus) § Contain very few organelles § Outnumber white blood cells 1000: 1 Copyright © 2006 Pearson Education, Inc. , publishing as Benjamin Cummings

Hemoglobin § Iron-containing protein § Binds strongly, but reversibly, to oxygen § Each hemoglobin molecule has four oxygen binding sites § Each erythrocyte has 250 million hemoglobin molecules Copyright © 2006 Pearson Education, Inc. , publishing as Benjamin Cummings

Leukocytes (White Blood Cells) § Crucial in the body’s defense against disease § These are complete cells, with a nucleus and organelles § Able to move into and out of blood vessels (diapedesis) § Can move by ameboid motion § Can respond to chemicals released by damaged tissues Copyright © 2006 Pearson Education, Inc. , publishing as Benjamin Cummings

Leukocyte Levels in the Blood § Normal levels are between 4, 000 and 11, 000 cells per microliter (μl) § Abnormal leukocyte levels § Leukocytosis § Above 11, 000 leukocytes/ μl § Generally indicates an infection § Leukopenia § Abnormally low leukocyte level § Commonly caused by certain drugs Copyright © 2006 Pearson Education, Inc. , publishing as Benjamin Cummings

Types of Leukocytes § Granules in their cytoplasm can be stained § Include neutrophils, eosinophils, and basophils Figure 10. 4 Copyright © 2006 Pearson Education, Inc. , publishing as Benjamin Cummings

Types of Leukocytes § Agranulocytes § Lack visible cytoplasmic granules § Include lymphocytes and monocytes Figure 10. 4 Copyright © 2006 Pearson Education, Inc. , publishing as Benjamin Cummings

Granulocytes § Neutrophils § Multilobed nucleus with fine granules § Act as phagocytes at active sites of infection § Eosinophils § Large brick-red cytoplasmic granules § Found in repsonse to allergies and parasitic worms Copyright © 2006 Pearson Education, Inc. , publishing as Benjamin Cummings

Granulocytes § Basophils § Have histamine-containing granules § Initiate inflammation Copyright © 2006 Pearson Education, Inc. , publishing as Benjamin Cummings

Agranulocytes § Lymphocytes § Nucleus fills most of the cell § Play an important role in the immune response § Monocytes § Largest of the white blood cells § Function as macrophages § Important in fighting chronic infection Copyright © 2006 Pearson Education, Inc. , publishing as Benjamin Cummings

Platelets § Derived from ruptured multinucleate cells called megakaryocytes. § Needed for the clotting process § Normal platelet count = 300, 000/μl Copyright © 2006 Pearson Education, Inc. , publishing as Benjamin Cummings

Hematopoiesis § Hematopoeisis is blood cell formation. § Occurs in red bone marrow § All blood cells are derived from a common stem cell (hemocytoblast … we saw these in a picture earlier) § Hemocytoblast differentiation § Lymphoid stem cell produces lymphocytes § Myeloid stem cell produces other formed elements Copyright © 2006 Pearson Education, Inc. , publishing as Benjamin Cummings

Fate of Erythrocytes § Unable to divide, grow, or synthesize proteins (Why? ). § Wear out in 100 to 120 days § When worn out, are eliminated by phagocytes in the spleen or liver § Lost cells are replaced by division of hemocytoblasts Copyright © 2006 Pearson Education, Inc. , publishing as Benjamin Cummings

Control of Erythrocyte Production § Erythropoiesis is formation of RBC’s § Rate is controlled by a hormone (erythropoietin) § Kidneys produce most erythropoietin as a response to reduced oxygen levels in the blood § Homeostasis is maintained by negative feedback from blood oxygen levels Copyright © 2006 Pearson Education, Inc. , publishing as Benjamin Cummings

Control of Erythrocyte Production Figure 10. 5 Copyright © 2006 Pearson Education, Inc. , publishing as Benjamin Cummings

Hemostasis § Stoppage of blood flow § Result of a break in a blood vessel § Hemostasis involves three phases § Platelet plug formation § Vascular spasms § Coagulation Copyright © 2006 Pearson Education, Inc. , publishing as Benjamin Cummings

Platelet Plug Formation § Collagen fibers are exposed by a break in a blood vessel § Platelets become “sticky” and cling to fibers § Anchored platelets release chemicals to attract more platelets § Platelets pile up to form a platelet plug Copyright © 2006 Pearson Education, Inc. , publishing as Benjamin Cummings

Vascular Spasms § Anchored platelets release serotonin § Serotonin causes blood vessel muscles to spasm § Spasms narrow the blood vessel, decreasing blood loss Copyright © 2006 Pearson Education, Inc. , publishing as Benjamin Cummings

Coagulation § Injured tissues release thromboplastin § PF 3 (a phospholipid) interacts with thromboplastin, blood protein clotting factors, and calcium ions to trigger a clotting cascade § Prothrombin activator converts prothrombin to thrombin (an enzyme) Copyright © 2006 Pearson Education, Inc. , publishing as Benjamin Cummings

Coagulation § Thrombin joins fibrinogen proteins into hairlike fibrin § Fibrin forms a meshwork (the basis for a clot) Copyright © 2006 Pearson Education, Inc. , publishing as Benjamin Cummings

Blood Clotting § Blood usually clots within 3 to 6 minutes § The clot remains as endothelium regenerates § The clot is broken down after tissue repair Copyright © 2006 Pearson Education, Inc. , publishing as Benjamin Cummings

Fibrin Clot Figure 10. 7 Copyright © 2006 Pearson Education, Inc. , publishing as Benjamin Cummings

Undesirable Clotting § Thrombus § A clot in an unbroken blood vessel § Can be deadly in areas like the heart § Embolus § A thrombus that breaks away and floats freely in the bloodstream § Can later clog vessels in critical areas such as the brain Copyright © 2006 Pearson Education, Inc. , publishing as Benjamin Cummings

Bleeding Disorders § Thrombocytopenia § Platelet deficiency § Even normal movements can cause bleeding from small blood vessels that require platelets for clotting § Hemophilia § Hereditary bleeding disorder § Normal clotting factors are missing Copyright © 2006 Pearson Education, Inc. , publishing as Benjamin Cummings

Blood Groups and Transfusions § Large losses of blood have serious consequences § Loss of 15 to 30 percent causes weakness § Loss of over 30 percent causes shock, which can be fatal § Transfusions are the only way to replace blood quickly § Transfused blood must be of the same blood group Copyright © 2006 Pearson Education, Inc. , publishing as Benjamin Cummings

Human Blood Groups § Blood contains genetically determined proteins § A foreign protein (antigen) may be attacked by the immune system § Blood is “typed” by using antibodies that will cause blood with certain proteins to clump (agglutination) Copyright © 2006 Pearson Education, Inc. , publishing as Benjamin Cummings

Human Blood Groups § There are over 30 common red blood cell antigens § The most vigorous transfusion reactions are caused by ABO and Rh blood group antigens Copyright © 2006 Pearson Education, Inc. , publishing as Benjamin Cummings

ABO Blood Groups § Based on the presence or absence of two antigens § Type A § Type B § The lack of these antigens is called type O Copyright © 2006 Pearson Education, Inc. , publishing as Benjamin Cummings

ABO Blood Groups § The presence of both A and B is called type AB § The presence of either A or B is called types A and B, respectively Copyright © 2006 Pearson Education, Inc. , publishing as Benjamin Cummings

Rh Blood Groups § Named because of the presence or absence of one of eight Rh antigens (agglutinogen D) § Most Americans are Rh+ § Problems can occur in mixing Rh+ blood into a body with Rh– blood Copyright © 2006 Pearson Education, Inc. , publishing as Benjamin Cummings

Rh Dangers During Pregnancy § Danger is only when the mother is Rh– and the father is Rh+, and the child inherits the Rh+ factor Copyright © 2006 Pearson Education, Inc. , publishing as Benjamin Cummings

Rh Dangers During Pregnancy § The mismatch of an Rh– mother carrying an Rh+ baby can cause problems for the unborn child § The first pregnancy usually proceeds without problems § The immune system is sensitized after the first pregnancy § In a second pregnancy, the mother’s immune system produces antibodies to attack the Rh+ blood (hemolytic disease of the newborn) Copyright © 2006 Pearson Education, Inc. , publishing as Benjamin Cummings

Blood Typing § Blood samples are mixed with anti-A and anti -B serum § Coagulation or no coagulation leads to determining blood type § Typing for ABO and Rh factors is done in the same manner § Cross matching – testing for agglutination of donor RBCs by the recipient’s serum, and vice versa Copyright © 2006 Pearson Education, Inc. , publishing as Benjamin Cummings

Blood Typing Figure 10. 8 Copyright © 2006 Pearson Education, Inc. , publishing as Benjamin Cummings

Developmental Aspects of Blood § Sites of blood cell formation § The fetal liver and spleen are early sites of blood cell formation § Bone marrow takes over hematopoiesis by the seventh month § Fetal hemoglobin differs from hemoglobin produced after birth Copyright © 2006 Pearson Education, Inc. , publishing as Benjamin Cummings
- Slides: 44